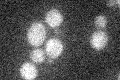
YCL028W
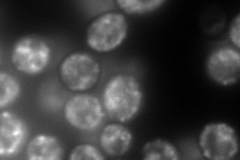
YCL028W
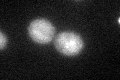
YCL028W

View description
[PIN(+)] prion, an infectious protein conformation that is generally an ordered protein aggregate
Localization:
Intensity:
Fold change:
Significance:
-
C’ GFP library in SD
below threshold17.6 -
N' NOP1pr-GFP in SD
punctate324.319 -
N' TEF2pr-mCherry in SD

punctate502.954 -
N' NATIVEpr-GFP in SD

punctate75.6031 -
N' TEF2pr-VC and Cyto-VN in SD

punctate49.957 -
C’ GFP library in SD+DTT
cytosol15.920.9No -
C’ GFP library in SD+H2O2

cytosol16.040.91No -
C’ GFP library in Starvation Media

cytosol12.670.71No -
C’ GFP library on the background of Pup2-DaMP

below threshold -
C’ GFP library on the background of CCT mutant

below threshold17.92231.01806No
